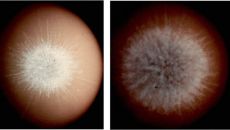

2026
일
월
화
수
목
금
토
-

LGU+, 소상공인 맞춤형 'SOHO 안심보상' 요금제 출시
LG유플러스는 소상공인 고객의 금융 피해 예방에 초점을 맞춘 신규 인터넷 요금제 'SOHO 안심보상'을 출시했다고 14일 밝혔- 2026-01-14 10:08
- 전자신문
-

국방부, 연천·철원 등 접경지 63만㎡ 군사시설보호구역 해제
[이데일리 김관용 기자] 국방부가 군사시설보호구역 규제를 합리화하고 국민 재산권 보장 및 지역균형발전을 뒷받침하기 위해 향후- 2026-01-14 10:08
- 이데일리
-

日, 11월 여행수지 흑자 19% 감소…"'대만 유사시' 발언 여파"
(서울=연합뉴스) 최이락 기자 = 다카이치 사나에 일본 총리의 지난해 11월 '대만 유사시' 시사 발언으로 촉발된 중일 갈등이- 2026-01-14 10:08
- 연합뉴스
-

대구사이버대-글로벌리더십대, 국제 교육 협력 네트워크 확대 '맞손'
글로벌 교육 네트워크 확대...공동 연구·교류 기반 구축 학생 교류와 공동 연구, 학술 출판 등 국제 협력 추진 대구사이버대학- 2026-01-14 10:08
- 머니투데이
-

프로농구 올스타전에 변준형 부상으로 빠지고 김낙현 대체 출전
(서울=연합뉴스) 오명언 기자 = 올 시즌 프로농구 '별들의 축제'에서 변준형(정관장)이 빠지고 김낙현(SK)이 대신 합류한다- 2026-01-14 10:08
- 연합뉴스
-
우주 불꽃놀이 보여준 초신성의 비밀 [우주를 보다]
[서울신문 나우뉴스] 고려 무신 정권 시대였던 1181년, 밤하늘에 갑자기 새로운 별이 나타났다. 이 별은 6개월 동안이나 관- 2026-01-14 10:08
- 서울신문
-

르노 신차에 SKT AI 탑재…차량용 에이전트 '에이닷 오토' 공개
SK텔레콤은 르노코리아의 신차 '필랑트'에 차세대 차량용 인공지능(AI) 에이전트인 '에이닷 오토'를 적용했다고 14일 밝혔다- 2026-01-14 10:08
- 아시아경제
-

트럼프, 파월 겨냥해 "곧 물러나길 바란다…후임 수주내 발표"(종합2보)
(워싱턴=연합뉴스) 박성민 홍정규 특파원 = 도널드 트럼프 미국 대통령은 13일(현지시간) 법무부로부터 기소 압박을 받는 제롬- 2026-01-14 10:08
- 연합뉴스
-

인천연구원 “신설 영종·검단구, 2030년 인구 46만 대비 기반시설 확보해야”
아시아투데이 박은영 기자 = 오는 7월 1일 인천시의 행정체제 개편으로 신설되는 '영종구'와 '검단구'가 자치구로서 온전한 기- 2026-01-14 10:08
- 아시아투데이
-

대구시, 수돗물 ‘불안요소’ 제거 노력···‘과불화화합물’ 2종 검사항목에 포함
대구시는 수돗물의 안전성을 높이기 위해 자체 검사항목을 확대한다고 14일 밝혔다. 대구상수도사업본부는 올해 원수 및 정수 검사- 2026-01-14 10:08
- 경향신문
-

KBO, 2026년 기록강습회 개최…1월 21일부터 접수
[OSEN=길준영 기자] KBO가 기록강습회를 개최한다. KBO는 14일 “2026년 KBO 기록강습회가 1월 30일(금)부터- 2026-01-14 10:08
- OSEN
-

엘리스그룹, 1900억 토큰 규모 한국어 AI 교육 데이터셋 공개
엘리스그룹은 한국어 교육용 인공지능(AI) 데이터셋 2종을 글로벌 오픈소스 플랫폼 허깅페이스에 공개했다고 14일 밝혔다. 이번- 2026-01-14 10:07
- 이투데이
-
KB국민카드, 디지털자산 연계 하이브리드 결제 기술 특허 출원
KB국민카드가 기존 카드 결제 인프라를 기반으로 디지털자산 활용 가능성을 확대하기 위한 하이브리드 결제 기술에 대한 특허를 출- 2026-01-14 10:07
- 이투데이
-

[단독] 슈퍼카 ‘벤틀리’, 청담동에 초호화 주택 짓는다[부동산360]
[헤럴드경제=서정은 기자] 벤틀리 모터스가 미국 마이애미에 이어 서울 강남구 청담동에 하이엔드 주택 ‘벤틀리 레지던스(Bent- 2026-01-14 10:07
- 헤럴드경제
-

한미반도체, 애플 출신 이명호 부사장 영입
[파이낸셜뉴스] 한미반도체가 미국 애플 출신 반도체 전문가 이명호 부사장을 영입했다고 14일 밝혔다. 이 부사장은 한미반도체에- 2026-01-14 10:07
- 파이낸셜뉴스


